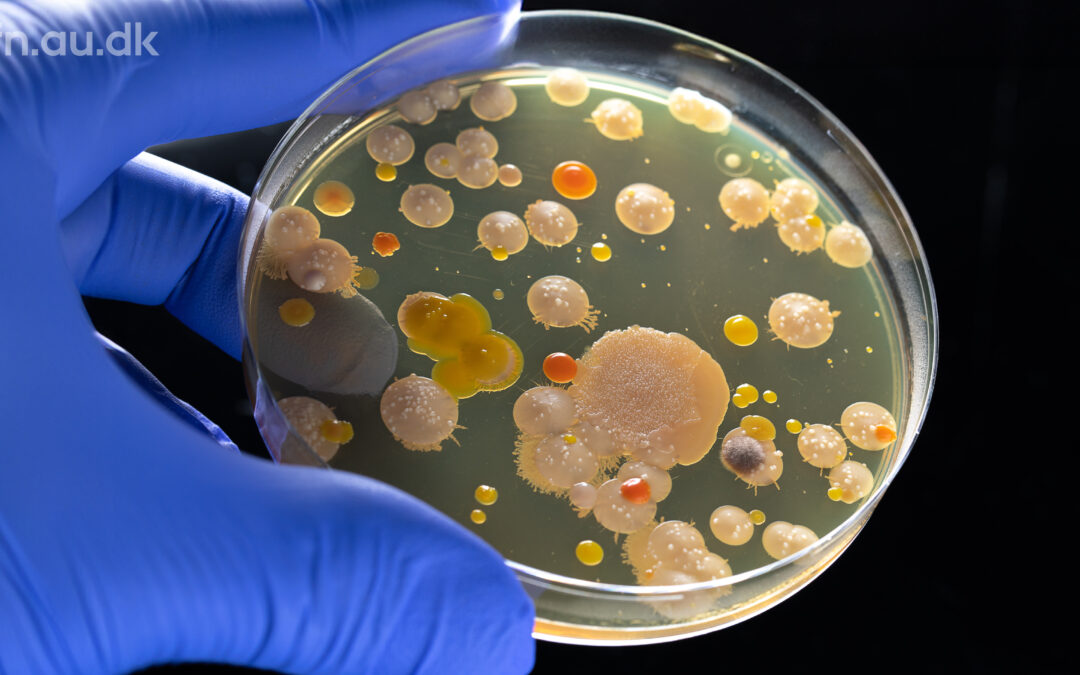

Med foredragsserien Offentlige foredrag i Naturvidenskab kan du komme tættere på de nyeste opdagelser og erkendelser inden for naturvidenskab.
Det er forskere som forelæser, niveauet er højt, og du vil blive udfordret, men du kan få udbytte af alle foredrag uanset dine faglige forudsætninger.
Aarhus Universitet (AU) tilbyder livestreaming af deres “Offentlige foredrag i Naturvidenskab” til omkring 400 værtssteder i Danmark og udlandet,- heriblandt Domus Felix.
Vil resistente bakterier slå os ihjel?
Et af de største fremskridt i lægevidenskaben er opdagelsen af antibiotika, men hvordan virker de egentlig og hvorfor rammer de ikke vores egne celler? Hør om bakterier, antibiotika og om mulige løsninger på de fremvindende resistente bakterier.
Det kan du blive klogere på tirsdag d. 6. maj, hvor de to forskere, Ditlev Brodersen og Hans Jørn Kolmos, holder et spændende foredrag om emnet.
Vel mødt på Bjælkeloftet!
Foredragsholdere
– Ditlev E. Brodersen, professor i strukturel mikrobiologi ved Institut for Molekylærbiologi og Genetik, Aarhus Universitet
– Hans Jørn Kolmos, professor i klinisk mikrobiologi, Klinisk institut, Syddansk Universitet
Program for livestreaming aftner
– 18:45 Kort intro
– 19:00 – 21:00 livestreaming af foredraget med indlagt pause, derefter er ordet frit. Gratis og uden tilmelding.
– Øl og vand kan købes.
– OBS! Indgang fra baggården. Arrangementerne finder sted på BJÆLKELOFTET.